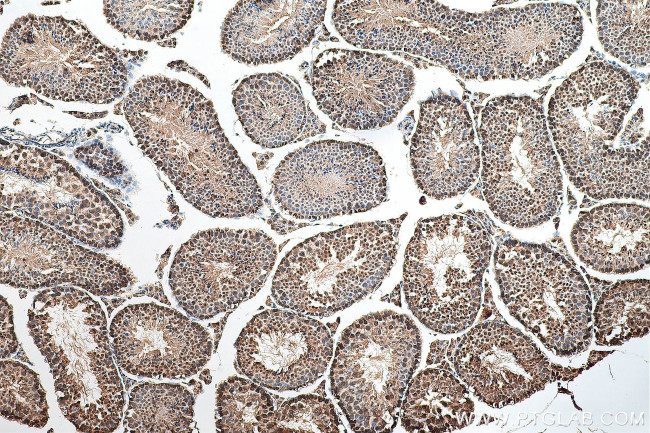
CDC2L6 Antibody in Immunohistochemistry (Paraffin) (IHC (P))

Search
Proteintech
CDC2L6 Polyclonal Antibody
{{$productOrderCtrl.translations['antibody.pdp.commerceCard.promotion.promotions']}}
{{$productOrderCtrl.translations['antibody.pdp.commerceCard.promotion.viewpromo']}}
{{$productOrderCtrl.translations['antibody.pdp.commerceCard.promotion.promocode']}}: {{promo.promoCode}} {{promo.promoTitle}} {{promo.promoDescription}}. {{$productOrderCtrl.translations['antibody.pdp.commerceCard.promotion.learnmore']}}
产品信息
13761-1-AP
种属反应
宿主/亚型
分类
类型
抗原
偶联物
形式
浓度
规格
纯化类型
保存液
内含物
保存条件
运输条件
产品详细信息
Immunogen sequence: MDYDFKAKL AAERERVEDL FEYEGCKVGR GTYGHVYKAR RKDGKDEKEY ALKQIEGTGI SMSACREIAL LRELKHPNVI ALQKVFLSHS DRKVWLLFDY AEHDLWHIIK FHRASKANKK PMQLPRSMVK SLLYQILDGI HYLHANWVLH RDLKPANILV MGEGPERGRV KIADMGFARL FNSPLKPLAD LDPVVVTFWY RAPELLLGAR HYTKAIDIWA IGCIFAELLT SEPIFHCRQE DIKTSNPFHH DQLDRIFSVM GFPADKDWED IRKMPEYPTL QKDFRRTTYA NSSLIKYMEK HKVKPDSKVF LLLQKLLTMD PTKRITSEQA LQDPYF (1-335 aa encoded by B C037289)
靶标信息
CDC2L6 is one of the components of the Mediator coactivator complex. The Mediator complex is a multiprotein complex required for transcriptional activation by DNA binding transcription factors of genes transcribed by RNA polymerase II. The protein encoded by this gene is similar to cyclin-dependent kinase 8 which can also be a component of the Mediator complex.
仅用于科研。不用于诊断过程。未经明确授权不得转售。
生物信息学
蛋白别名: CDC2-related protein kinase 6; CDK8-like cyclin-dependent kinase; cell division cycle 2-like 6 (CDK8-like); Cell division cycle 2-like protein kinase 6; Cell division protein kinase 19; cyclin-dependent kinase (CDC2-like) 11; Cyclin-dependent kinase 11; Cyclin-dependent kinase 19; Death-preventing kinase; DPK; unnamed protein product
基因别名: 2700084L06Rik; AI845279; AW228747; bA346C16.3; CDC2L6; CDK11; CDK19; DEE87; EIEE87; KIAA1028; mKIAA1028
UniProt ID: (Human) Q9BWU1, (Mouse) Q8BWD8
Entrez Gene ID: (Human) 23097, (Mouse) 78334, (Rat) 309804